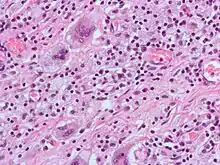

Célula gigante
Uma célula gigante é uma massa de vários núcleos formada a partir da união de macrófagos, que muitas vezes forma granulomas.[1] Ao redor desta célula existe uma camada de fibroblastos, que com o tempo depositam colágeno, tal que substitui todo o granuloma por uma cicatriz mielinizada.
Células gigantes multinucleadas devido a uma infeção; coloração H&E.
Referências
- National Library of Medicine - Medical Subject Headings. «Giant Cells». Consultado em 12 de fevereiro de 2015
This article is issued from Wikipedia. The text is licensed under Creative Commons - Attribution - Sharealike. Additional terms may apply for the media files.